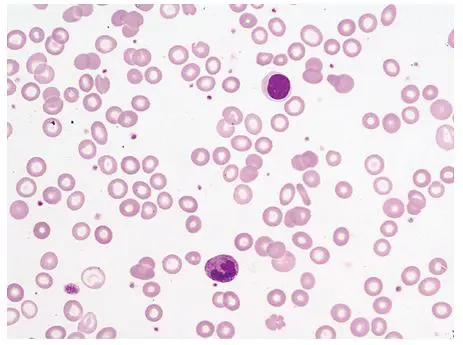
圖片描述

112年:(醫檢)血液(1)
病人有慢性腸道出血,周邊血液抹片如圖所示。下列敘述何者與抹片結果最不相關?
A紅血球平均血色素濃度(MCHC)下降
B紅血球平均血色素重量(MCH)下降
C網狀紅血球數上升
D紅血球平均大小(MCV)下降
詳細解析
本題觀念:
慢性腸道出血導致鐵缺乏性貧血,其典型周邊血象為微小球(microcytosis)、低血色素(hypochromia)型紅血球;相應地,RBC 指標包括 MCV、MCH、MCHC 均降低,而骨髓中因缺鐵而無法適當增生,網織紅血球(reticulocyte)計數往往不會明顯上升。
影像分析:
從提供的抹片可見:
- 紅血球大小不一(anisocytosis),多數顆粒偏小,明顯小於正常細胞直徑,符合 microcytosis 特徵。
- 紅血球中央透明區(central pallor)增大,顏色淡薄,呈低血色素性(hypochromia)。
- 未見大量多染性紅血球(polychromasia),周邊幾乎無明顯網織紅血球釋出,顯示骨髓補償不足。
整體所見與鐵缺乏性貧血相符,非溶血或急性失血型貧血無顯著網織紅血球。
選項分析
-
選項 A:紅血球平均血色素濃度(MCHC)下降
解釋:低血色素性紅血球反映單位體積內血紅素濃度下降,即 MCHC 降低。微小球低血色素性貧血常見此指標降低。 (hematology.mlsascp.com) -
選項 B:紅血球平均血色素重量(MCH)下降
...(解析預覽)...

升級 VIP 解鎖圖文解析